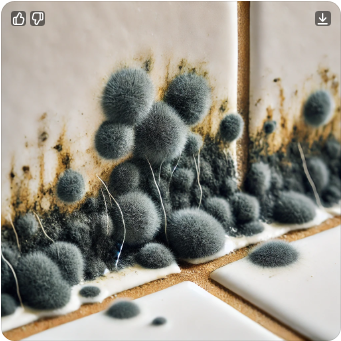

【욕실 곰팡이 제거법】초보도 5분이면 끝! ✦ 완전 제거 루틴 6단계 공개
✔ 곰팡이 제거제 써도 며칠이면 다시 올라오는 검은 곰팡이
✔ 타일 줄눈 사이에 낀 찌든 곰팡이
✔ 곰팡이 없애고 싶지만, 힘들이긴 싫다구요?
☞ 확실하게 없애는 방법, 지금 바로 보러가기
🔗 곰팡이 제거 꿀팁 확인하기

⬇ 목차
- 욕실 곰팡이, 왜 생기고 왜 안 없어질까?
- 【욕실 곰팡이 제거법】 6단계 루틴
- 내가 실천한 곰팡이 제거 성공기
- 곰팡이 예방 꿀팁
- 자주 묻는 Q&A
- 마무리 + 추가 정보 링크
✦ 1. 욕실 곰팡이, 왜 생기고 왜 안 없어질까?
욕실은 습기가 많은 구조라
곰팡이가 자라기 너무 좋은 환경이에요.
타일 틈새, 실리콘 줄눈, 천장 모서리 등
눈에 보이지 않는 부분까지 곰팡이 번식지가 숨어 있어요.
→ 그런데 곰팡이 제거제만 뿌리고 끝내면,
표면만 제거되고 뿌리는 그대로 남아있어요.
그래서 우리는 이제부터
"뿌리까지 제거하는 진짜 루틴"으로 가야 합니다!



✦ 2. 【욕실 곰팡이 제거법】 6단계 루틴
✅ 하루 10분이면 충분!
곰팡이 박멸 루틴, 따라만 해보세요.
① 곰팡이 핫스팟 파악하기
→ 타일 사이, 실리콘 줄눈, 천장 모서리, 세면대 아래쪽
눈에 잘 안 띄는 부분까지 확인!
② 락스 or 곰팡이 제거제+키친타월 팩하기
→ 곰팡이 부위에 제거제를 뿌리고 키친타월로 덮기
→ 20~30분 방치 후 제거 → 효과 2배!
③ 칫솔로 문질러 제거하기
→ 줄눈 사이, 코너는 칫솔 or 나무꼬치로 긁듯이 문지르기
→ 힘 조절은 약~중간으로, 타일 손상 주의
④ 뜨거운 물로 헹구기
→ 세제 찌꺼기 + 곰팡이 잔여물 깨끗하게 제거
⑤ 베이킹소다 + 식초 활용법 (2차 소독)
→ 곰팡이 제거 후 2차로 식초와 베이킹소다로 소독하면
재번식 억제에 좋아요!
⑥ 완전히 건조시키기
→ 곰팡이의 90%는 습기 때문에 생김!
→ 제습기, 선풍기, 창문 환기 활용해서 말리기

✦ 3. 내가 실천한 곰팡이 제거 성공기
저는 예전에 세면대 옆 실리콘 줄눈에 까만 곰팡이가
도저히 안 없어져서 스트레스였어요.
인터넷 보고 따라 해도 소용없고…
결국 찾은 방법이 “키친타월 곰팡이 팩”
→ 락스를 듬뿍 적신 키친타월을 곰팡이 위에 얹어 30분 방치
→ 떼어보니 검은곰팡이가 싹!
→ 그 후엔 식초소다로 마무리 소독!
지금은 한 달에 한 번만 점검해도 말끔~
✦ 4. 곰팡이 예방 꿀팁
- 매일 샤워 후 창문 열기 + 문 열어두기
- 바닥 물기 밀대로 제거 or 수건 닦기
- 천장, 벽 타일도 주 1회 닦기
- 제습제 or 숯통 욕실에 두기
- 실리콘 교체는 1년에 한 번 정도가 이상적


✦ 5. 자주 묻는 Q&A
Q. 락스 말고 천연 재료로 가능한가요?
A. 네! 베이킹소다+식초도 효과 있어요. 다만 심한 곰팡이는 락스 권장
Q. 곰팡이 제거제 뿌리고 바로 닦아도 되나요?
A. ❌ 절대 NO! 20~30분은 방치 후 닦아야 뿌리 제거돼요
Q. 실리콘 곰팡이는 왜 안 없어지나요?
A. 실리콘 자체에 스며든 곰팡이는 교체가 답입니다!
✦ 6. 마무리 + 실천 링크
욕실 곰팡이 제거, 어렵지 않아요!
중요한 건
✔︎ “표면 청소”가 아니라
✔︎ “뿌리까지 제거 + 건조 습관”입니다.
오늘 당장 시작해보세요~
🔗 생활정리 꿀팁 모음 보기